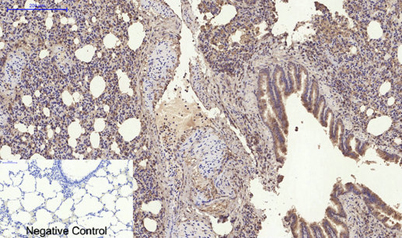

Overview
-
 Immunofluorescence analysis of A549. 1,primary Antibody(red) was diluted at 1:200(4°C overnight). 2, Goat Anti Rabbit IgG (H&L) - Alexa Fluor 594 Secondary antibody was diluted at 1:1000(room temperature, 50min).3, Picture B: DAPI(blue) 10min.
Immunofluorescence analysis of A549. 1,primary Antibody(red) was diluted at 1:200(4°C overnight). 2, Goat Anti Rabbit IgG (H&L) - Alexa Fluor 594 Secondary antibody was diluted at 1:1000(room temperature, 50min).3, Picture B: DAPI(blue) 10min. -
 Immunohistochemical analysis of paraffin-embedded Human-uterus tissue. 1,RANKL Polyclonal Antibody was diluted at 1:200(4°C,overnight). 2, Sodium citrate pH 6.0 was used for antibody retrieval(>98°C,20min). 3,Secondary antibody was diluted at 1:200(room tempeRature, 30min). Negative control was used by secondary antibody only.
Immunohistochemical analysis of paraffin-embedded Human-uterus tissue. 1,RANKL Polyclonal Antibody was diluted at 1:200(4°C,overnight). 2, Sodium citrate pH 6.0 was used for antibody retrieval(>98°C,20min). 3,Secondary antibody was diluted at 1:200(room tempeRature, 30min). Negative control was used by secondary antibody only. -
Immunohistochemical analysis of paraffin-embedded Rat-lung tissue. 1,RANKL Polyclonal Antibody was diluted at 1:200(4°C,overnight). 2, Sodium citrate pH 6.0 was used for antibody retrieval(>98°C,20min). 3,Secondary antibody was diluted at 1:200(room tempeRature, 30min). Negative control was used by secondary antibody only.
Immunohistochemical analysis of paraffin-embedded Rat-lung tissue. 1,RANKL Polyclonal Antibody was diluted at 1:200(4°C,overnight). 2, Sodium citrate pH 6.0 was used for antibody retrieval(>98°C,20min). 3,Secondary antibody was diluted at 1:200(room tempeRature, 30min). Negative control was used by secondary antibody only. -
 Immunohistochemical analysis of paraffin-embedded Mouse-kidney tissue. 1,RANKL Polyclonal Antibody was diluted at 1:200(4°C,overnight). 2, Sodium citrate pH 6.0 was used for antibody retrieval(>98°C,20min). 3,Secondary antibody was diluted at 1:200(room tempeRature, 30min). Negative control was used by secondary antibody only.
Immunohistochemical analysis of paraffin-embedded Mouse-kidney tissue. 1,RANKL Polyclonal Antibody was diluted at 1:200(4°C,overnight). 2, Sodium citrate pH 6.0 was used for antibody retrieval(>98°C,20min). 3,Secondary antibody was diluted at 1:200(room tempeRature, 30min). Negative control was used by secondary antibody only.
关闭
在线咨询
Online consultation
-
在线咨询
-
技术支持

关注微信公众号



 下载说明 ①
下载说明 ①





